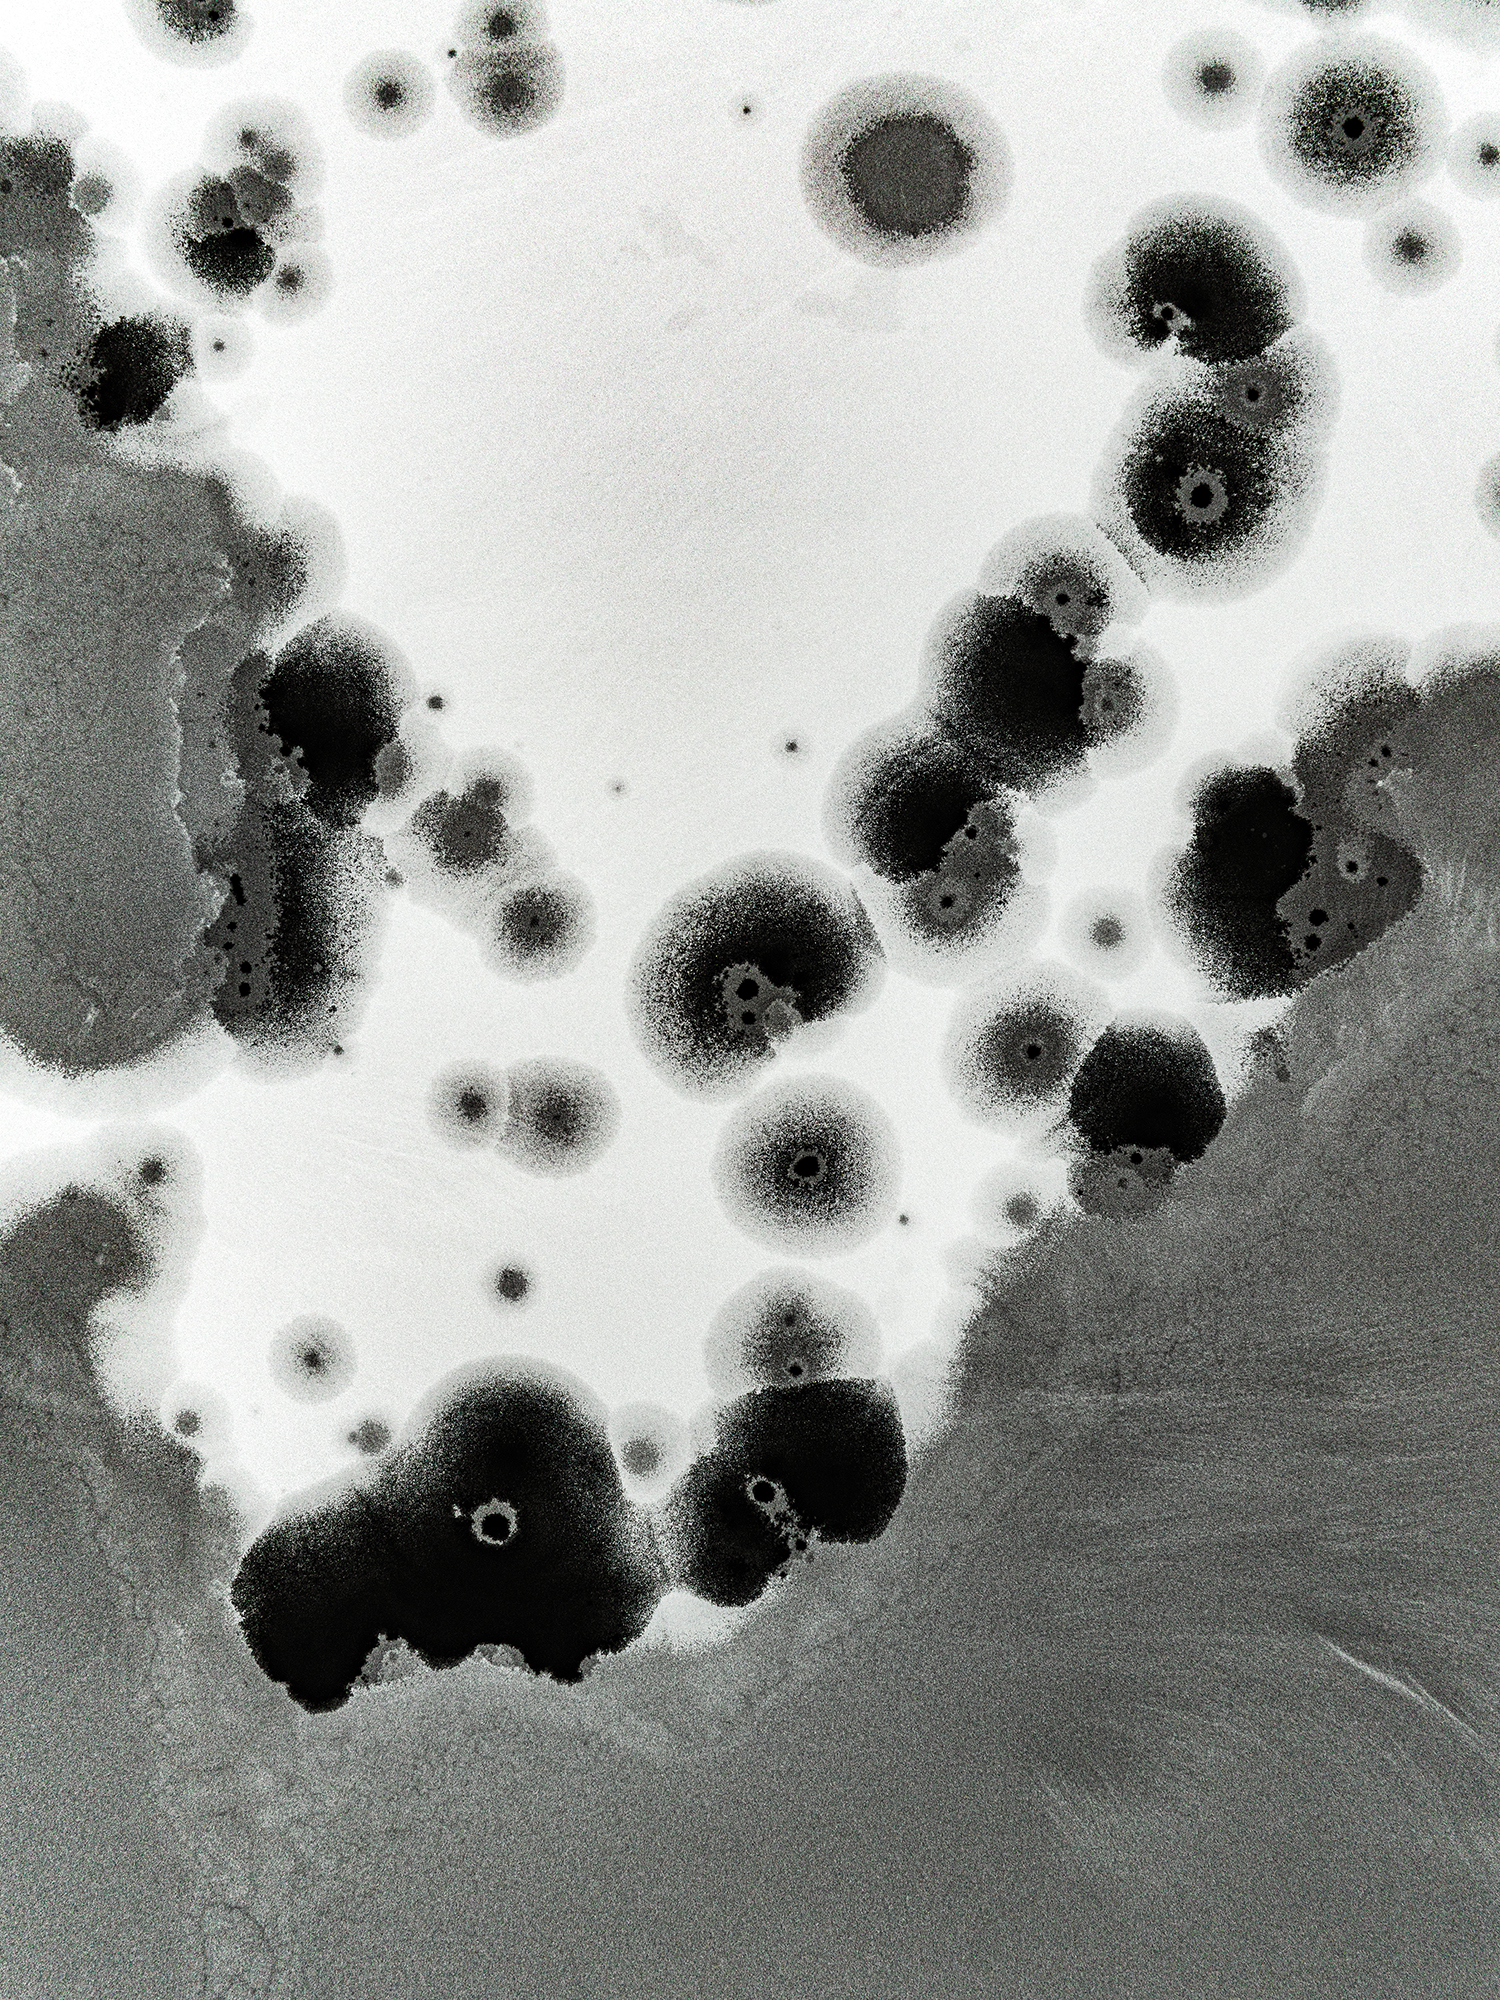
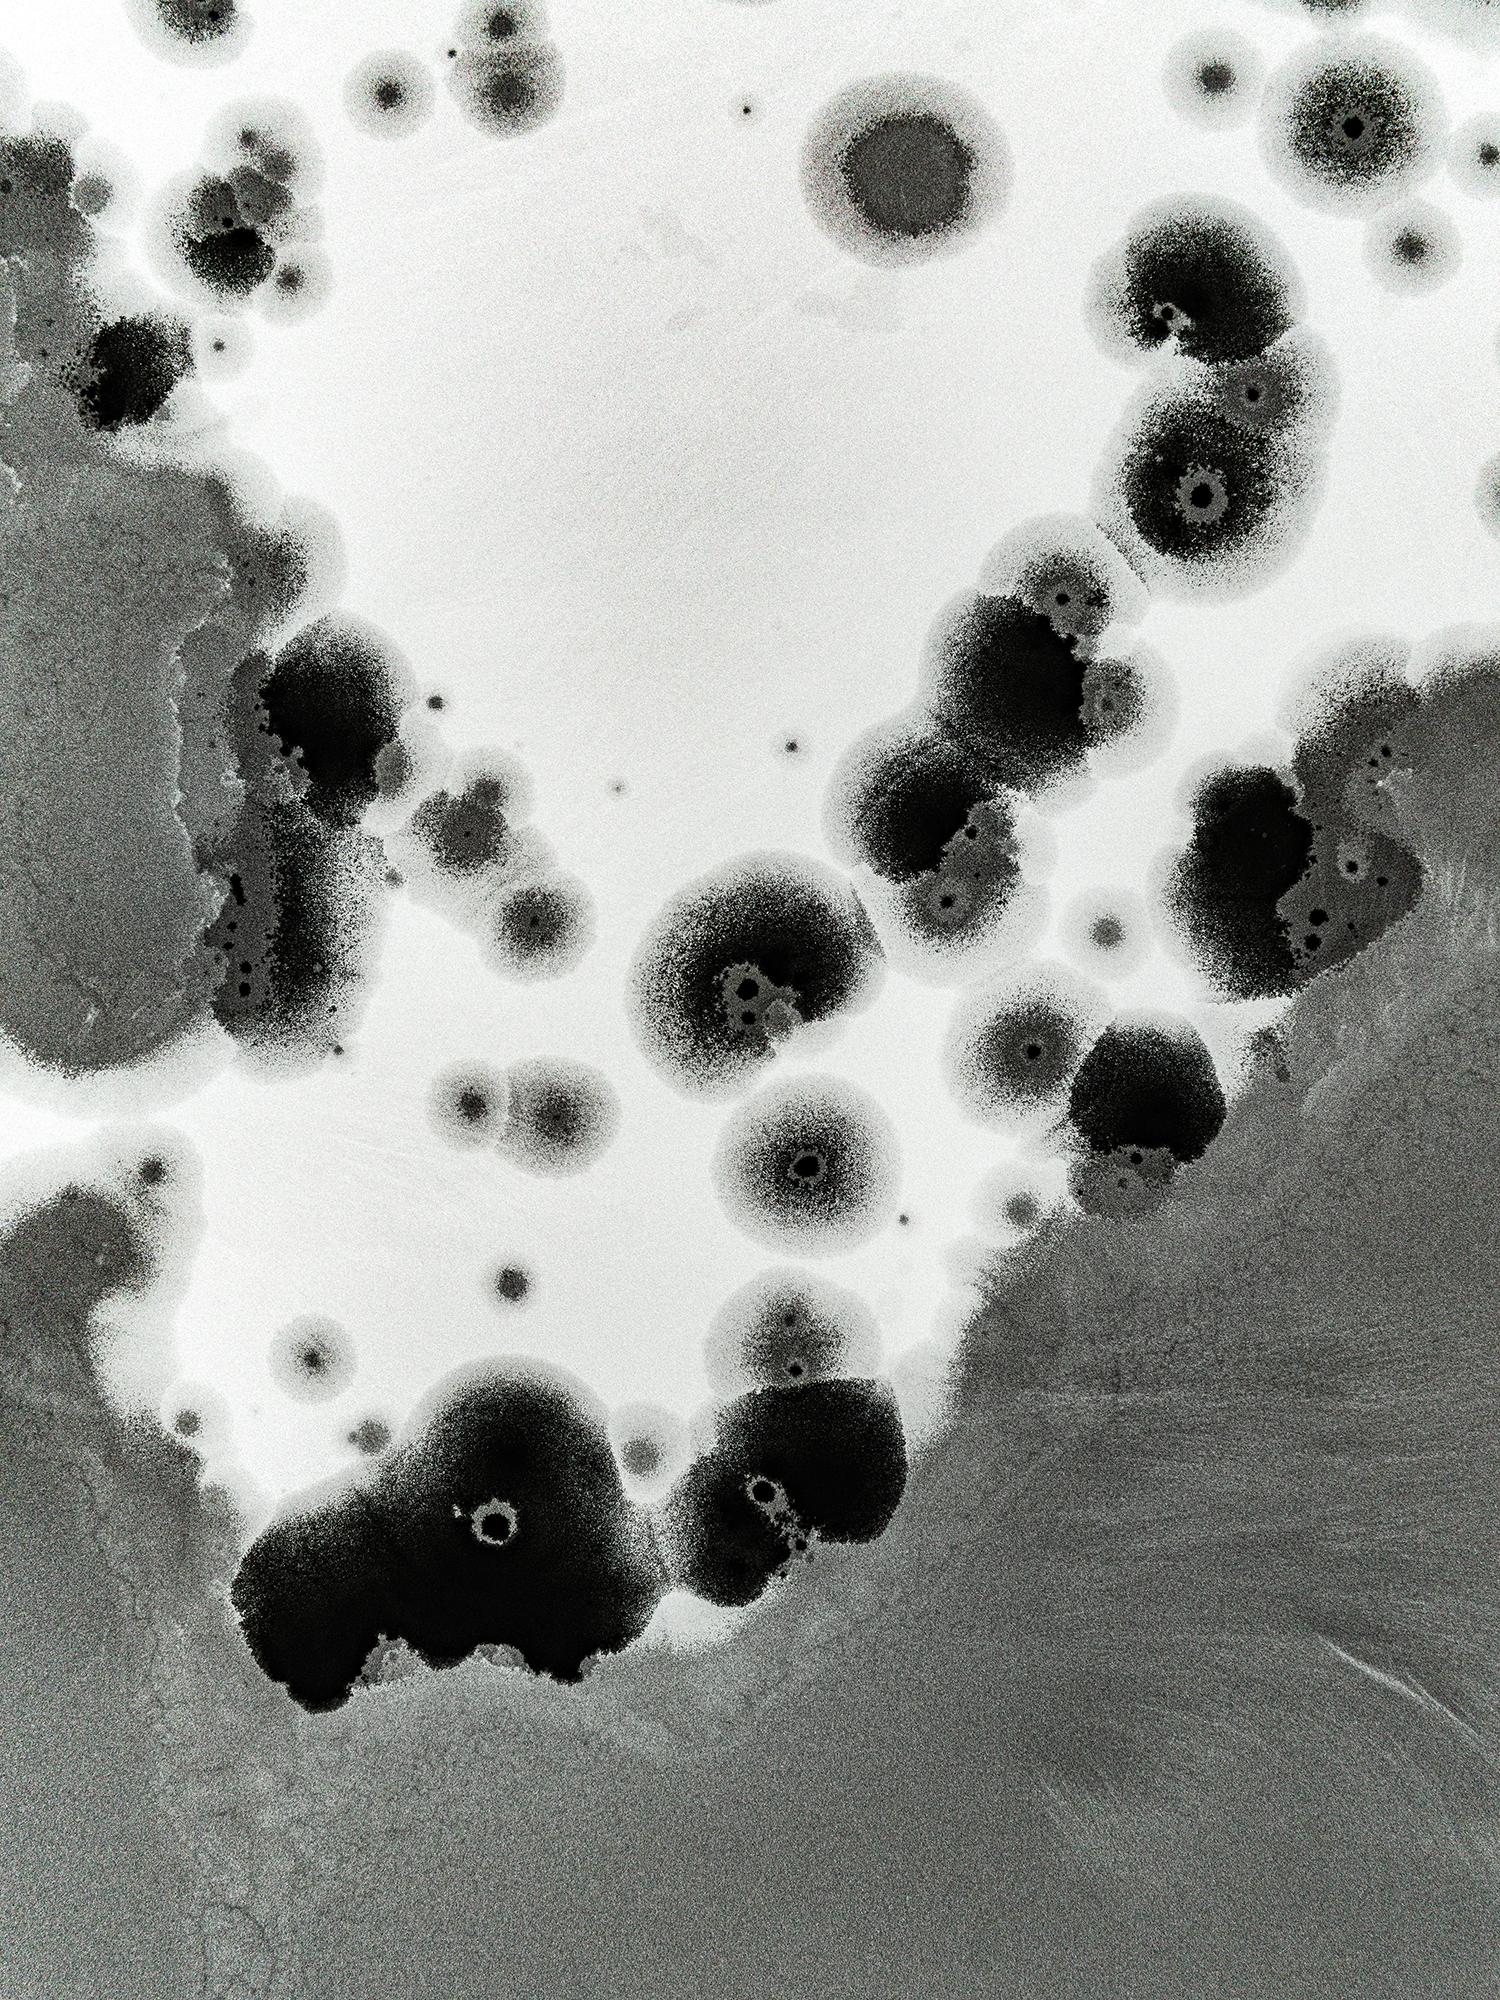

Reborn captures momentary drawings born from the repeated cycle of life's energy. The photographs were taken from the air above wetlands in Japan’s Yamagata Prefecture that have formed within volcanic craters from eruptions tens of thousands of years ago. Here, snow mixes with water and turns to ice as temperatures drop. As the sun rises, the ice returns to a liquid, revealing delicate patterns when the landscape is viewed from above. These patterns change repeatedly due to slight changes in temperature, the amount of snow, the wind, heat from wetland plants and the slightest flow of water. The unpredictability of these events, which repeat like the cycle of life, remind Kazuaki Koseki of the moment when a living creature is reborn.
Born into a family photo studio business, of which he is the eldest son. With photos forming a familiar part of his life since early childhood, now conducts his private photographic work while running the studio he has since taken over.
Koseki forges his way into the wilderness of Yamagata and Tohoku,evoking the five senses through the four seasons, and has dedicated himself to capturing the natural majesty of the area in many of his works, including in his landmark series Summer Fairies.